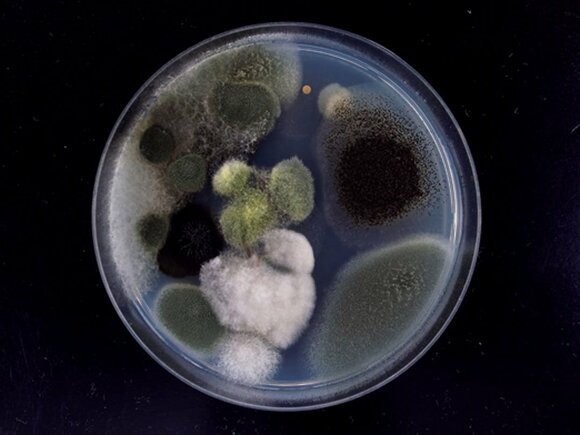
ゲタ箱内の土ボコリからアオカビなどを検出

カビ・ダニは家中のいたるところで発生しますが、ついつい後回しにしてしまいがちなのがゲタ箱です。そこで、ESSEレポーターのHさんのお宅にカビ・ダニ博士の川上裕司さんがお邪魔して、見落としがちなリビングを徹底チェック。退治&予防法を掃除のプロ・高橋敬子さんに聞きました。
ゲタ箱からアオカビ、傘立ても雨水の影響でカビが発生!
<ゲタ箱>つめ込みすぎや土ボコリがたまるとカビのリスク大
すべての画像を見る(全3枚)ゲタ箱内の土ボコリを調べたところ、木材などを劣化させるアオカビなどを検出しました。「靴に付着した土に潜むカビの胞子などが繁殖することも」と川上さん。
靴をぎっちり収納しているHさん宅のゲタ箱。カビ対策のためにと、棚の奥に十円玉がありますが…。
「置いただけでは銅の効果は期待できません。それよりもカビが繁殖しない環境にすることが肝心です」と川上さんから対策のススメがありました。
【退治法】
玄関ドアをあけてから靴をすべて取り出し、ホコリを掃除機で吸い取ります。塩素系漂白剤の液でかたく絞った布で棚板をふき、水ぶきで仕上げたら、扉をあけてしばらく換気をしましょう。
【予防法】
靴はつめ込みすぎず、ゲタ箱内の通気性を確保。棚板に新聞紙を敷いておくと、土ボコリがゲタ箱内に飛び散るのを防止できます。定期的に新聞紙を交換して換気も心がけてみてください。
<靴>梅雨どきの革靴はカビが心配。帰宅後は十分乾燥を
靴そのものもケアが必要です。「一日履いた靴は汗でかなりの湿気を含むうえ、梅雨どきは雨水や泥で汚れやすく、革にカビが生える危険大」と川上さん。泥汚れや汚水は新聞紙の上で落とし、十分に乾かしてからゲタ箱にしまうことが大事です。
【退治法】
革靴のカビは、表面についた小さなものなら落とせることも。消毒用エタノールを布につけ、目立たない場所でシミや色落ちなどをテストしてから、そっとふき取ってください。
【予防法】
一日履いた靴はたたきにひと晩置いて湿気を飛ばし、ホコリをふき取ってからゲタ箱へ。雨の日はたたきに新聞紙を敷きつめ、その上で靴を乾かせば、早く乾きます。
また、翌朝丸めて捨てれば、汚水に潜むカビの定着予防になります。
<傘立て>雨水がたまるとカビも増殖。定期的にケアを
雨水をためたままにしがちで、意外と汚れやすいのが傘立て。「雨水はカビの胞子を含んでいるので、傘がビショビショのまま入れておくと、カビ発生の危険が。においの原因にもなります」(川上さん)。
【退治法】
水受け皿は取り外して雨水を捨て、水でかたく絞った布で汚れをふき取ります。泥や土ボコリがついているときは、汚れを払い落としてから水ぶきし、天日干しにしてよく乾かします。
【予防法】
傘はよく水気をきってから傘立てへ。受け皿の水はためておかず、こまめに捨てましょう。晴れたら天日干しにして、傘が完全に乾いてからしまってください。
※本記事はESSE2015年7月号の記事を再構成したものです